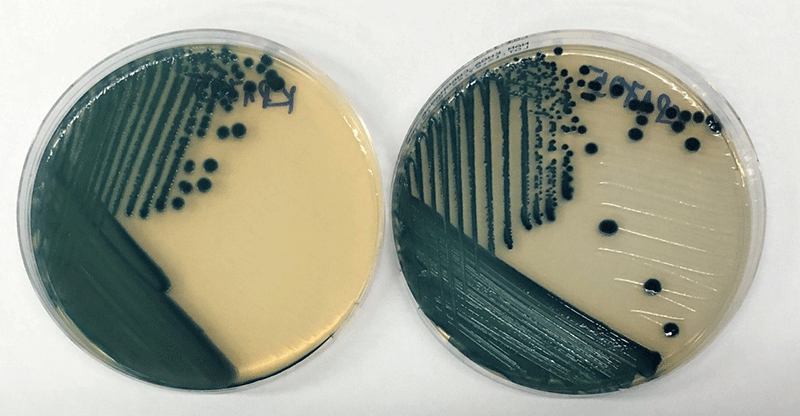
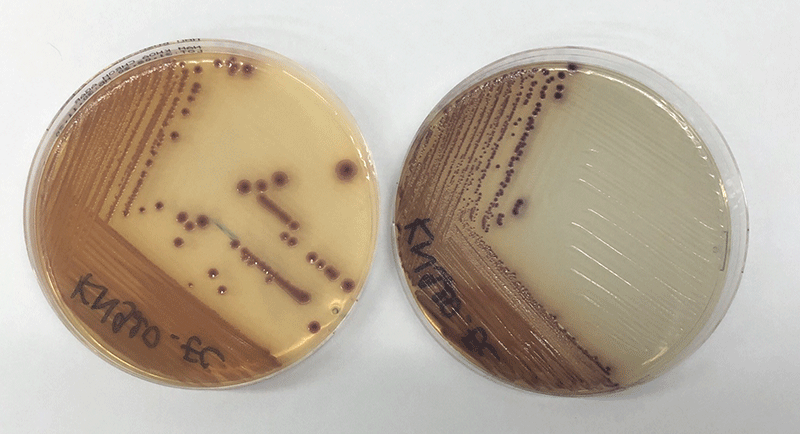

Sản xuất thành công đĩa thạch chẩn đoán nhiễm khuẩn đường ruột
TNNN - ThS Trần Chí Thành (Trường ĐH Nguyễn Tất Thành) cùng các cộng sự đã nghiên cứu và sản xuất thành công đĩa thạch ChromAgar CRE dùng chẩn đoán và sàng lọc nhanh vi khuẩn đường ruột kháng carbapenem với giá thành rẻ bằng ¼ so với hàng tương đương nhập ngoại và hạn sử dụng lâu hơn gấp 3 lần.
ThS Thành cho biết, hiện nay khoảng một nửa số bệnh nhân đang điều trị trong các bệnh viện ở Việt Nam mang vi khuẩn đường ruột đa đề kháng, có khả năng kháng carbapenems (nhóm kháng sinh có phổ tác dụng rộng nhất trong số các nhóm kháng sinh hiện hành).
Vi khuẩn đường ruột kháng carbapenem (Carbapenem Resistant Enterobacteriaceae - CRE) kháng lại gần như tất cả các loại kháng sinh, khiến cho việc điều trị nhiễm trùng do các vi khuẩn này gây ra rất khó khăn. Bên cạnh đó, CRE có thể chuyển các gene kháng kháng sinh cho các loại vi khuẩn khác, dẫn đến việc các vi khuẩn này cũng kháng với các loại kháng sinh carbapenem. Các vi khuẩn đường ruột có thể lan truyền một cách dễ dàng và trở thành nguyên nhân gây ra nhiều loại nhiễm trùng, chủ yếu là nhiễm trùng đường tiết niệu, máu và viêm phổi.
Màu sắc khuẩn lạc (xanh đen) của Kleb.pneumoniae kháng carbapenem
trên đĩa ChromAgar CRE Ảnh: TCT
Để chẩn đoán và sàng lọc nhanh CRE, các bệnh viện thường sử dụng đĩa CRE (loại đĩa thạch bằng thủy tinh hoặc chất dẻo dạng hình trụ, có nắp đậy) để nuôi cấy vi sinh vật, định lượng tổng khuẩn… Loại đĩa này thường được nhập khẩu từ châu Âu, với giá thành khoảng 10 USD/đĩa. Đĩa có thời hạn sử dụng chỉ khoảng 4 tuần, thậm chí ngắn hơn và có thể giảm chất lượng do quá trình vận chuyển, bảo quản.
Đĩa thạch ChromAgar CRE mà nhóm nghiên cứu và sản xuất với công thức riêng có thời hạn sử dụng lên đến 12 tuần (bảo quản ở điều kiện 2 - 8°C), giá thành chỉ khoảng 2,5 USD/chiếc.
Màu sắc khuẩn lạc (hồng đậm) của E.coli kháng carbapenem trên
đĩa ChromAgar CRE Ảnh: TCT
ChromAgar CRE là môi trường sinh màu, có thành phần là ChromAgar Orientation, dùng phát hiện và phân biệt trực khuẩn Gram âm (-) kháng với carbapenem. ChromAgar CRE phân biệt vi khuẩn dựa trên màu sắc do thủy giải cơ chất của β-glucosidase và β-galactosidase. Môi trường có bổ sung muối mật (bile salt) và thuốc nhuộm crystal violet để ức chế vi khuẩn Gram dương (+) và bổ sung 2µg/mL meropenem để phát hiện vi khuẩn không nhạy với carbapenem.
Đĩa thạch ChromAgar CRE đã thử nghiệm tại một số bệnh viện như Việt-Tiệp (Hải Phòng), Đại học Y dược TPHCM,…cho kết quả tương đương với đĩa nhập ngoại, có thể sàng lọc tỷ lệ vi khuẩn CRE với độ nhạy cao (97,4%), độ đặc hiệu 98,8%, đặc biệt là E. coli và nhóm KESC (Klebsiella, Enterobacter, Serratia, hoặc Citrobacter).
Hiện nhóm nghiên cứu mong muốn hợp tác với các đơn vị có năng lực sản xuất quy mô lớn để cung ứng sản phẩm cho thị trường trong nước và mở rộng xuất khẩu.
Nguồn: Khoa học & Phát triển
Tin khác
Ấn tượng Lễ trao giải Cuộc thi vẽ tranh “Bảo vệ môi trường trong học đường – Sân trường mơ ước của em”
“Thắp lửa trái tim” – Lan tỏa yêu thương, gần 700 triệu đồng gửi về vùng cao
Phát động Cuộc thi vẽ tranh Bảo vệ môi trường trong học đường lần thứ II
Gần 750 bác sĩ nhận bằng tốt nghiệp
Văn phòng AOSC phối hợp cùng QUATEST 3 và Vinatest thực hiện chuyên đề giới thiệu ISO 15189
Tin cũ hơn
Trung tâm Đo lường – Nhà máy Z176: Không ngừng hoàn thiện hệ thống quản lý theo tiêu chuẩn ISO/IEC 17025:2017
Gần 1.000 bài viết tham dự cuộc thi “Vượt lên số phận” lần thứ VII
Sắp diễn ra giải bóng đá "Báo chí đồng hành cùng doanh nghiệp"
Lan toả chương trình trồng cây "Đường xanh" đến cộng đồng
Đã có gần 18.000 người tham gia Chiến dịch "Triệu bước chân nhân ái"